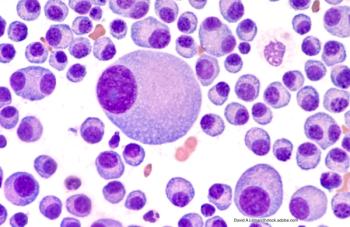

The COVID-19 pandemic revealed the advantages of treatment that involved fewer in-person office visits, according to recent research.
The COVID-19 pandemic revealed the advantages of treatment that involved fewer in-person office visits, according to recent research.

GSK plc has announced positive results for safety and tolerance of Jemperli (dostarlimab; GSK plc) in treating women with endometrial cancer.

A confirmatory trial of Tecentriq in urothelial carcinoma failed to meet the co-primary endpoint of overall survival.

This is the first FDA-approved ADC for platinum-resistant disease, according to ImmunoGen.

As the main course of treatment for cancer-related pain, the use of opioids comes with a number of issues for both patients and prescribers.

Timing of treatment initiation is crucial for patients with cancer.

Collecting data on social determinants of health carries a number of issues and needs to be improved to create learning health systems.

While the use of chemotherapy at end of life is decreasing, the use of immunotherapy is increasing.

Follow-ups from pharmacists show a significant increase in outpatient antiemetic drugs prescribed and quality of life in patients experiencing chemotherapy-induced nausea and vomiting.

Tackling Medicare Part D drug costs takes more than just capping costs.

Childhood cancer survivors are high risk of pain and in need of pain relief. Did 2016 guidelines for opioid prescribing change use in this group?

The study looked at cancer patients as a group, but senior author notes that ‘that treatments for blood cancers are very costly and many of them require treatment for long periods of time.’

Because it is ‘off the shelf,’ Tecvayli may have advantages over the CAR-T therapies, which are custom made for each patient and involve harvesting the patient's T cells.

Escalating costs are hitting patients hard. CMS price negotiation and the $2,000 cap on Part D out-of-pocket expenses should benefit many patients with Medicare coverage.

Pre-pandemic survey examines effects of heart disease, asthma, and more.

Cancer care is expensive, but pharmacists can help.

Patients who received the chemotherapies paclitaxel and docetaxel were at an increased risk of adverse events of the eye.

More of these treatments have been approved, but supply chain issues and cost remain obstacles.

Researchers report that half of the online pharmacies are rogue operations that may operate without a license or have other serious shortcomings.

The researchers attributed low adherence to oral anti-cancer medications for blood cancer and certain other cancers to high monthly out-of-pocket among several other reasons.

New research suggests there was a 53% greater 5-year risk of cardiovascular disease in men with type 2 diabetes who received a GnRH agonist for prostate cancer compared with their counterparts who did not receive GnRH agonists.

This is the first approved therapy targeted to patients with the HER2-low breast cancer subtype. Its approval comes four months ahead of its PDUFA action date.

The specialty drug pipeline includes first- and next-in- class drugs across the oncology and immunology spaces.

Bar code medication administration has been moved beyond inpatient areas, but compliance may require improvement.

The pipeline includes next-in-class treatments for melanoma, NSCLC, breast cancer, and multiple myeloma.